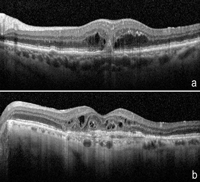

Volumen 22 - Número 5 - Diciembre 2014
Tomografía de coherencia óptica en la degeneración macular asociada a la edad
RP. Casaroli-Marano1,4, R. Gallego-Pinazo2,4, L. Arias Barquet3,4, S. Alforja1
1Departamento de Cirugía (Facultad de Medicina). Instituto Clínic de Oftalmología. Hospital Clínic de Barcelona. Universidad de Barcelona. Barcelona.
2Unidad de Mácula. Servicio de Oftalmología. Hospital Universitario y Politécnico La Fe. Valencia.
3Servicio de Oftalmología. Hospital Universitario de Bellvitge. Universidad de Barcelona. L’Hospitalet de Llobregat. Barcelona.
4RETICS-OftaRed. Instituto de Salud Carlos III. Madrid.
CORRESPONDENCIA
Ricardo P. Casaroli-Marano
E-mail: rcasaroli@ub.edu
E-mail: rcasaroli@ub.edu
A pesar de los recientes avances terapéuticos, la degeneración macular asociada a la edad (DMAE) se perfila como uno de los mayores problemas de salud pública ocular en la actualidad. Siendo la principal causa de ceguera legal en los países industrializados, afecta aproximadamente al 20-35% de la población con edad superior a los 80 años, y se espera que en la próxima década esta condición vea incrementada su prevalencia 1,5 veces debido al aumento de la esperanza de vida de la población en general y a una mayor prevalencia de los factores de riesgo asociados1.
La DMAE se puede clasificar en etapas tempranas, intermedias y avanzadas. Inicialmente puede ser asintomática, con signos limitados a drusas y alteraciones pigmentarias maculares (maculopatía asociada a la edad, MAE), pero tiende a ser progresiva y da lugar a la aparición de metamorfopsia, escotoma central y disminución de la visión2,3 en etapas intermedias y sobre todo avanzadas (DMAE).
Desde el punto de vista clínico, las etapas avanzadas tienen dos formas de presentación: atrofia geográfica (DMAE seca o atrófica) y exudativa (DMAE húmeda o neovascular). La primera representa aproximadamente el 80-90% de las presentaciones clínicas de la enfermedad, y se caracteriza por una degeneración lenta y progresiva del epitelio pigmentario de la retina (EPR) y las capas externas de la retina neurosensorial (RNS), principalmente la de los fotorreceptores. En la forma atrófica, el mecanismo fisiopatológico aún no ha sido definido con precisión, pero se cree que pueda ocurrir debido a un proceso de inflamación crónica que implica varios factores asociados con las vías de activación del complemento y el estrés oxidativo3,4.
La forma exudativa representa sólo el 10-15% de la forma avanzada de la enfermedad, pero es la causa del mayor porcentaje de pérdida de visión central. La DMAE exudativa aparece a partir de un proceso angiogénico en el que vasos neoformados de la coroides (neovascularización coroidea; NVC) invaden la RNS en el área macular2,3. Existe amplia evidencia científica que implica al factor de crecimiento endotelial vascular (VEGF) como elemento fundamental en la fisiopatología de la DMAE exudativa5,6. Estos hallazgos han dado paso a una nueva era en el tratamiento de la NVC, sobre la base de una mejor comprensión de los mecanismos celulares y moleculares asociados con la enfermedad. Los fármacos antiangiogénicos, que se utilizan para bloquear las vías de acción del VEGF, representan un avance importante para el tratamiento de esta forma clínica de la patología7-10.
Sin embargo, no existen tratamientos específicos y eficaces para la atrofia geográfica ni para sus consecuencias sobre la estructura y la función del área macular. En este sentido, el Age-Related Eye Disease Study (AREDS)11,12 demostró que la administración de suplementos antioxidantes específicos (formulación AREDS) reduce el riesgo de progresión de la DMAE de las etapas intermedias (definido como la presencia de varias drusas de tamaño medio o la presencia de una o más drusas grandes) hacia etapas avanzadas de la enfermedad, lo que constituye una estrategia terapéutica preventiva11-13.
El método clásico para la detección y el seguimiento clínico de las lesiones asociadas a la DMAE, principalmente en sus estadios temprano e intermedio, es, con ciertas limitaciones, la fotografía en color (retinografía) de la retina para la visualización de las drusas y las alteraciones pigmentarias en la mácula. Estas pueden ser clasificadas y evaluadas cuantitativamente. Otras técnicas de imagen no invasivas más recientes, tales como la tomografía de coherencia óptica (OCT), la autofluorescencia del fondo ocular (FAF) y la imagen térmica o en infrarrojo (IR), constituyen avances significativos para el estudio y el seguimiento clínico de la MAE y la DMAE14,15. Las técnicas más invasivas, como la angiografía con fluoresceína (AGF) y la angiografía con verde de indocianina (ICG), que requieren la administración de medios de contraste en la circulación, son opciones válidas para delimitar el estado clínico de la alteración macular con más precisión14.
Un aspecto a destacar es que la SD-OCT en la DMAE permite demostrar el componente exudativo relacionado con la permeabilidad anormal de la NVC. Además, las imágenes con SD-OCT pueden analizar directamente el impacto de la NVC en las capas externas de la retina y evaluar las alteraciones estructurales de los fotorreceptores (región de los elipsoides de los segmentos internos, segmentos externos y zona de interdigitación con el EPR) y del EPR16,17.
Así, la OCT es una herramienta fundamental para casi todos los aspectos relacionados con el paciente con DMAE, y su valor real gana dimensión en la DMAE exudativa. La SD-OCT contribuye a establecer las pautas de tratamiento y retratamiento, además de ayudar a controlar la eficacia o el fracaso de este, convirtiéndose así en parte esencial de la exploración en la práctica clínica del seguimiento de la DMAE exudativa17,18.
La SD-OCT resulta de utilidad en la atrofia geográfica para el seguimiento de los procesos de atrofia del EPR y las capas externas de la retina, y además permite una evaluación cuantitativa de la amplitud del área central afectada por la evolución clínica de la atrofia. En imágenes de alta resolución puede definirse la afectación de las diferentes capas retinianas. Los cambios y las alteraciones de perfiles del EPR debido a la presencia de drusas por debajo de él, o los propios de los depósitos drusenoides subretinianos o pseudodrusas reticulares por encima, son fácilmente identificables con secciones tomográficas de alta resolución19.
En las formas de DMAE exudativa, las aplicaciones y las ventajas de la SD-OCT son innumerables. Las secciones únicas o el estudio de mapeado macular son muy adecuados para la identificación del fluido subretiniano (FSR) y de sus alteraciones, así como para la clasificación de los tipos de NVC presentes20: a) tipo 1, por debajo del EPR; b) tipo 2, por encima del EPR; c) tipo 3 o proliferación angiomatosa retiniana (RAP); así como también las formas mixtas.
Otras condiciones neovasculares que pueden delinearse con SD-OCT son la vasculopatía coroidea polipoidal y las membranas neovasculares subretinianas (MNVSR) peripapilares17. A pesar de la versatilidad de la OCT, no remplaza por completo a la AGF. Las aplicaciones clínicas comunes de la OCT en el ámbito de la DMAE exudativa incluyen el diagnóstico y la decisión de iniciar el tratamiento, las decisiones relacionadas con el curso evolutivo del tratamiento, las decisiones de retratamiento y las decisiones para la finalización de la pauta terapéutica17,18.
Las drusas aparecen como elevaciones o irregularidades por debajo de la capa del EPR, a modo de excrecencias en la membrana de Bruch (Figura 1). Pueden observarse como ondulaciones tenues del contorno de la capa hiperreflectiva correspondiente al complejo EPR-membrana de Bruch-coriocapilar (EPR-Br-cc). Los desprendimientos drusenoides se producen por confluencia de drusas blandas y aparecen como elevaciones más extensas del complejo EPR-Br-cc, con contenido hiperreflectivo heterogéneo (Figura 2). El diagnóstico diferencial tomográfico deberá realizarse con los DEP serosos, que son predominantemente hiporreflectivos17,19-21 (Figura 2).
En los DEP, la imagen hiperreflectiva correspondiente al complejo EPR-Br-cc presenta una elevación bien delimitada, localizada y en ángulos rectos con forma de semicírculo. En el área del DEP, el EPR frecuentemente presenta un aumento de la reflectividad, secundario a una alteración en el índice de refracción entre la coriocapilar y el FSR, o por el sufrimiento de las células del EPR. Este aumento de la reflectividad a nivel del complejo EPR-Br-cc puede causar una atenuación de la imagen tomográfica correspondiente a los vasos de la coroides (capas de Sattler y Haller) (Figura 2). Un enmascaramiento de la coroides subyacente puede evidenciarse en los DEP fibrovasculares y hemorrágicos, debido a la hiperreflectividad de su contenido subyacente (“lleno” hiperreflectivo). Este hecho no se observa en los DEP serosos, debido a la ausencia de reflectividad de su contenido (“vacío” hiperreflectivo) (Figura 2). La aparición de pequeños puntos de reflectividad heterogénea puede asociarse a la existencia de depósitos sub-EPR, debido a la presencia de lípidos o fibrina17,19-22,24.
Las REP pueden verse como pérdida del perfil del EPR (normalmente en forma de cúpula debido a la presencia de un DEP) asociado con una hiperreflectividad adyacente al EPR que se encuentra plegado24.
La identificación precoz de la NVC es esencial para un mejor pronóstico, desde que el tratamiento con fármacos bloqueadores de la acción del VEGF confiere mayores oportunidades para una estabilización de la visión y, algunas veces, su mejoría. Así, en fases muy iniciales, la identificación precisa de una NVC mediante AGF puede ser difícil, desde que pequeños complejos neovasculares con actividad mínima presentan peculiaridades típicas que dificultan un diagnóstico definitivo. En estos casos, la SD-OCT podrá identificar pequeñas manifestaciones exudativas en la RNS y seriadas en el tiempo, debido a su característica de generar imágenes de alta resolución. La evaluación minuciosa de pequeñas áreas hiporreflectivas, correspondientes a la presencia de FSR, localizadas en la RNS externa (principalmente en la capa de los fotorreceptores), puede mostrar actividad incipiente de exudación (Figura 3). Asimismo, la presencia de alteraciones estructurales en el complejo EPR-Br-cc con lesiones tomográficas de reflectividad heterogénea pueden representar un complejo de vasos de neoformación a partir de la coroides17,19-21.
La NVC aparece como áreas de engrosamiento de la capa del EPR. Las MNVSR con componente clásico generalmente muestran una disposición de engrosamiento subretiniano más fusiforme, mientras que las MNVSR ocultas son habitualmente más irregulares y variables cuando se observan con secciones tomográficas transversales. Las NVC más profundas suelen ser poco visibles. Sin embargo, el estudio de las características de la NVC mediante OCT, para delinear y localizar las MNVSR, no es tan útil como la AGF. No obstante, cualquier modificación estructural del área macular, así como los cambios en la evolución de un EM, asociado o no a un tratamiento, son fácilmente identificables mediante OCT17,19,21.
Cualquier edema intraretiniano aparecerá como espacios quísticos en la RNS, pudiendo o no coexistir con un desprendimiento por acúmulo de FSR. Se debe tener en consideración la interpretación de los acúmulos de espacios con fluido (quistes) intraretinianos observados en el curso evolutivo de la patología, fácilmente identificables en la SD-OCT (Figura 3). Su presencia no implica necesariamente actividad de la NVC. El fluido en las capas de la RNS puede representar quistes degenerativos inactivos o tubulaciones de la retina externa, que son hallazgos comunes de los procesos degenerativos de la retina, incluyendo la DMAE (Figura 3). La correcta interpretación de los aspectos tomográficos de la retina puede evitar un tratamiento innecesario.
En las fases más avanzadas de la enfermedad, una actividad neovascular residual puede ser de difícil identificación debido al componente cicatricial o fibrótico asociado. En estos casos, las lesiones inactivas están relacionadas con hallazgos tomográficos de adelgazamiento de la RNS subyacente, mientras que los diferentes grados de actividad de la enfermedad pueden estar asociados a algún grado de aumento del grosor de la RNS, que se origina por la colección de fluido intraretiniano o subretiniano.
Las cicatrices en la retina o el EPR aparecen como áreas de mayor reflectividad de las capas externas de la retina, con áreas circundantes hiporreflectivas17,21. Los defectos angiográficos “en ventana”, correspondientes a la atrofia del EPR, muestran una retrodispersión altamente reflectante de la coroides debido al aumento de penetración de la señal en el tejido.
La SD-OCT presenta un importante valor para el seguimiento clínico y la evolución de las alteraciones estructurales de la región macular relacionadas con los mecanismos de disminución de la visión en la atrofia geográfica. Como ya se ha mencionado, las alteraciones relacionadas con el EPR pueden identificarse como áreas focales hiperreflectivas asociadas a “sombras” ópticas adyacentes. La atrofia geográfica se identifica como un área localizada de adelgazamiento de las capas externas de la RNS y del complejo EPR-Br-cc. La coroides subyacente presenta un aumento de la reflectividad debido a una mayor penetración de la luz, por el adelgazamiento de la retina (Figura 4). Puede delimitarse la región de transición entre la retina atrófica y el tejido normal, lo que sirve como referencia de medida en los exámenes realizados de manera seriada (Figura 4). En general, el análisis del mapa de grosor de la retina permitirá evaluar el área de extensión de la región atrófica y monitorizar su progresión. No obstante, con el advenimiento de la FAF, el cálculo de la progresión del área de atrofia gana precisión. Las áreas de atrofia macular suelen presentar medidas de grosor inferiores a 190 µm, en comparación con las medidas consideradas normales, de entre 220 y 270 µm17,19,21.
La DMAE se puede clasificar en etapas tempranas, intermedias y avanzadas. Inicialmente puede ser asintomática, con signos limitados a drusas y alteraciones pigmentarias maculares (maculopatía asociada a la edad, MAE), pero tiende a ser progresiva y da lugar a la aparición de metamorfopsia, escotoma central y disminución de la visión2,3 en etapas intermedias y sobre todo avanzadas (DMAE).
Desde el punto de vista clínico, las etapas avanzadas tienen dos formas de presentación: atrofia geográfica (DMAE seca o atrófica) y exudativa (DMAE húmeda o neovascular). La primera representa aproximadamente el 80-90% de las presentaciones clínicas de la enfermedad, y se caracteriza por una degeneración lenta y progresiva del epitelio pigmentario de la retina (EPR) y las capas externas de la retina neurosensorial (RNS), principalmente la de los fotorreceptores. En la forma atrófica, el mecanismo fisiopatológico aún no ha sido definido con precisión, pero se cree que pueda ocurrir debido a un proceso de inflamación crónica que implica varios factores asociados con las vías de activación del complemento y el estrés oxidativo3,4.
La forma exudativa representa sólo el 10-15% de la forma avanzada de la enfermedad, pero es la causa del mayor porcentaje de pérdida de visión central. La DMAE exudativa aparece a partir de un proceso angiogénico en el que vasos neoformados de la coroides (neovascularización coroidea; NVC) invaden la RNS en el área macular2,3. Existe amplia evidencia científica que implica al factor de crecimiento endotelial vascular (VEGF) como elemento fundamental en la fisiopatología de la DMAE exudativa5,6. Estos hallazgos han dado paso a una nueva era en el tratamiento de la NVC, sobre la base de una mejor comprensión de los mecanismos celulares y moleculares asociados con la enfermedad. Los fármacos antiangiogénicos, que se utilizan para bloquear las vías de acción del VEGF, representan un avance importante para el tratamiento de esta forma clínica de la patología7-10.
Sin embargo, no existen tratamientos específicos y eficaces para la atrofia geográfica ni para sus consecuencias sobre la estructura y la función del área macular. En este sentido, el Age-Related Eye Disease Study (AREDS)11,12 demostró que la administración de suplementos antioxidantes específicos (formulación AREDS) reduce el riesgo de progresión de la DMAE de las etapas intermedias (definido como la presencia de varias drusas de tamaño medio o la presencia de una o más drusas grandes) hacia etapas avanzadas de la enfermedad, lo que constituye una estrategia terapéutica preventiva11-13.
El método clásico para la detección y el seguimiento clínico de las lesiones asociadas a la DMAE, principalmente en sus estadios temprano e intermedio, es, con ciertas limitaciones, la fotografía en color (retinografía) de la retina para la visualización de las drusas y las alteraciones pigmentarias en la mácula. Estas pueden ser clasificadas y evaluadas cuantitativamente. Otras técnicas de imagen no invasivas más recientes, tales como la tomografía de coherencia óptica (OCT), la autofluorescencia del fondo ocular (FAF) y la imagen térmica o en infrarrojo (IR), constituyen avances significativos para el estudio y el seguimiento clínico de la MAE y la DMAE14,15. Las técnicas más invasivas, como la angiografía con fluoresceína (AGF) y la angiografía con verde de indocianina (ICG), que requieren la administración de medios de contraste en la circulación, son opciones válidas para delimitar el estado clínico de la alteración macular con más precisión14.
Aplicaciones de la OCT en DMAE
La OCT de dominio espectral (SD-OCT), con sus variantes, es en la actualidad ampliamente utilizada para el diagnóstico y el seguimiento clínico tanto de los estadios clínicos iniciales como de las formas avanzadas de DMAE, ya que tiene la capacidad de capturar aspectos relacionados con el área y el volumen del área macular. Permite el registro de las alteraciones y de las características morfométricas de la retina, el EPR y la coroides mediante secciones ópticas, y el mapeado de la anatomía por capas de la RNS y el EPR16-18. Los tomógrafos ópticos de última generación proporcionan información sobre el estado macular en tiempo real, con una resolución superior a la de la resonancia magnética y los ultrasonidos. Añade la ventaja de ofrecer información volumétrica en tres dimensiones del área macular, además de la visualización clara y precisa de manera individual de las capas y sus relaciones16-18. Una de sus grandes utilidades es que también permite evaluaciones repetidas en las mismas zonas de la retina durante el seguimiento longitudinal en el tiempo de un paciente, lo que resulta en una valoración más precisa de los efectos del tratamiento y de la evolución clínica del cuadro macular.Un aspecto a destacar es que la SD-OCT en la DMAE permite demostrar el componente exudativo relacionado con la permeabilidad anormal de la NVC. Además, las imágenes con SD-OCT pueden analizar directamente el impacto de la NVC en las capas externas de la retina y evaluar las alteraciones estructurales de los fotorreceptores (región de los elipsoides de los segmentos internos, segmentos externos y zona de interdigitación con el EPR) y del EPR16,17.
Así, la OCT es una herramienta fundamental para casi todos los aspectos relacionados con el paciente con DMAE, y su valor real gana dimensión en la DMAE exudativa. La SD-OCT contribuye a establecer las pautas de tratamiento y retratamiento, además de ayudar a controlar la eficacia o el fracaso de este, convirtiéndose así en parte esencial de la exploración en la práctica clínica del seguimiento de la DMAE exudativa17,18.
La SD-OCT resulta de utilidad en la atrofia geográfica para el seguimiento de los procesos de atrofia del EPR y las capas externas de la retina, y además permite una evaluación cuantitativa de la amplitud del área central afectada por la evolución clínica de la atrofia. En imágenes de alta resolución puede definirse la afectación de las diferentes capas retinianas. Los cambios y las alteraciones de perfiles del EPR debido a la presencia de drusas por debajo de él, o los propios de los depósitos drusenoides subretinianos o pseudodrusas reticulares por encima, son fácilmente identificables con secciones tomográficas de alta resolución19.
En las formas de DMAE exudativa, las aplicaciones y las ventajas de la SD-OCT son innumerables. Las secciones únicas o el estudio de mapeado macular son muy adecuados para la identificación del fluido subretiniano (FSR) y de sus alteraciones, así como para la clasificación de los tipos de NVC presentes20: a) tipo 1, por debajo del EPR; b) tipo 2, por encima del EPR; c) tipo 3 o proliferación angiomatosa retiniana (RAP); así como también las formas mixtas.
Otras condiciones neovasculares que pueden delinearse con SD-OCT son la vasculopatía coroidea polipoidal y las membranas neovasculares subretinianas (MNVSR) peripapilares17. A pesar de la versatilidad de la OCT, no remplaza por completo a la AGF. Las aplicaciones clínicas comunes de la OCT en el ámbito de la DMAE exudativa incluyen el diagnóstico y la decisión de iniciar el tratamiento, las decisiones relacionadas con el curso evolutivo del tratamiento, las decisiones de retratamiento y las decisiones para la finalización de la pauta terapéutica17,18.
Hallazgos más frecuentes en la DMAE
La SD-OCT puede identificar signos asociados con la actividad exudativa de la NVC, tales como FSR, quistes intraretinianos, aumento de grosor de la retina, desprendimiento del EPR (DEP) o roturas del EPR (REP). Por otra parte, permite analizar la progresión de la atrofia geográfica, detectar la evolución de esta hacia formas vasculares, diagnosticar DEP drusenoides y analizar morfométricamente los tipos y la evolución de las drusas presentes17-22.Drusas y desprendimientos drusenoides
La RNS y el EPR sufren alteraciones continuas a lo largo del tiempo. Habitualmente, los límites entre el envejecimiento y los procesos degenerativos en el área macular son sutiles y forman parte de un mismo proceso. Estas alteraciones morfológicas pueden ser difusas o focales. Las drusas son depósitos focales que se desarrollan en la cara externa de la membrana de Bruch, y con el paso del tiempo interfieren en el metabolismo de la retina neurosensorial17.Las drusas aparecen como elevaciones o irregularidades por debajo de la capa del EPR, a modo de excrecencias en la membrana de Bruch (Figura 1). Pueden observarse como ondulaciones tenues del contorno de la capa hiperreflectiva correspondiente al complejo EPR-membrana de Bruch-coriocapilar (EPR-Br-cc). Los desprendimientos drusenoides se producen por confluencia de drusas blandas y aparecen como elevaciones más extensas del complejo EPR-Br-cc, con contenido hiperreflectivo heterogéneo (Figura 2). El diagnóstico diferencial tomográfico deberá realizarse con los DEP serosos, que son predominantemente hiporreflectivos17,19-21 (Figura 2).

Figura 1. Drusas. Aparecen como irregularidades del EPR (a, b), con reflectividad heterogénea. En algunas ocasiones las drusas pueden sufrir un proceso de calcificación secundaria, dando origen a las drusas calcificadas, que se presentan como imágenes localizadas hiperreflectivas en el complejo EPR-membrana de Bruch (b). Las alteraciones pigmentarias, asociadas a los diferentes estadios de la DMAE, aparecen como puntos hiperreflectivos en las diferentes capas de la RNS (a, b).

Figura 2. Desprendimiento del EPR. Los desprendimientos drusenoides se originan por coalescencia de drusas y se observan como elevaciones irregulares, multilobuladas, más o menos extensas, del complejo EPR-Br-cc, con contenido hiperreflectivo heterogéneo (a). Los DEP serosos y fibrovasculares presentan elevaciones en cúpula bien delimitadas del EPR (b, c), algunas veces con ángulo recto en los bordes (b, c), debido a la fuerte adherencia entre el EPR y la membrana de Bruch. En los DEP fibrovasculares puede haber un enmascaramiento de la coroides subyacente con hiperreflectividad de su contenido (c, “lleno” hiperreflectivo). Los DEP serosos presentan generalmente ausencia o muy baja reflectividad de su contenido (b, “vacío” hiperreflectivo). Son frecuentes los acúmulos de FSR en la base de los DEP (b, c).
Desprendimientos y roturas del EPR
El DEP se caracteriza por la elevación en cúpula bien delimitada del EPR, algunas veces con ángulo recto en los bordes, debido a la fuerte adherencia entre el EPR y la membrana de Bruch, a través de su lámina basal. Los mecanismos de formación de un DEP son: a) la NVC; b) el aumento de la permeabilidad de la coriocapilar asociada a una pérdida de adhesión del EPR con la membrana de Bruch, que normalmente ocurre en presencia de drusas confluentes; y c) el aumento de la permeabilidad de la coriocapilar asociado a la descompensación del EPR23.En los DEP, la imagen hiperreflectiva correspondiente al complejo EPR-Br-cc presenta una elevación bien delimitada, localizada y en ángulos rectos con forma de semicírculo. En el área del DEP, el EPR frecuentemente presenta un aumento de la reflectividad, secundario a una alteración en el índice de refracción entre la coriocapilar y el FSR, o por el sufrimiento de las células del EPR. Este aumento de la reflectividad a nivel del complejo EPR-Br-cc puede causar una atenuación de la imagen tomográfica correspondiente a los vasos de la coroides (capas de Sattler y Haller) (Figura 2). Un enmascaramiento de la coroides subyacente puede evidenciarse en los DEP fibrovasculares y hemorrágicos, debido a la hiperreflectividad de su contenido subyacente (“lleno” hiperreflectivo). Este hecho no se observa en los DEP serosos, debido a la ausencia de reflectividad de su contenido (“vacío” hiperreflectivo) (Figura 2). La aparición de pequeños puntos de reflectividad heterogénea puede asociarse a la existencia de depósitos sub-EPR, debido a la presencia de lípidos o fibrina17,19-22,24.
Las REP pueden verse como pérdida del perfil del EPR (normalmente en forma de cúpula debido a la presencia de un DEP) asociado con una hiperreflectividad adyacente al EPR que se encuentra plegado24.
DMAE neovascular
Se caracteriza por la presencia de una NVC, determinada por AGF, que puede o no estar asociada a otros elementos característicos angiográficos y que forman un “complejo neovascular” o lesión neovascular25,26.La identificación precoz de la NVC es esencial para un mejor pronóstico, desde que el tratamiento con fármacos bloqueadores de la acción del VEGF confiere mayores oportunidades para una estabilización de la visión y, algunas veces, su mejoría. Así, en fases muy iniciales, la identificación precisa de una NVC mediante AGF puede ser difícil, desde que pequeños complejos neovasculares con actividad mínima presentan peculiaridades típicas que dificultan un diagnóstico definitivo. En estos casos, la SD-OCT podrá identificar pequeñas manifestaciones exudativas en la RNS y seriadas en el tiempo, debido a su característica de generar imágenes de alta resolución. La evaluación minuciosa de pequeñas áreas hiporreflectivas, correspondientes a la presencia de FSR, localizadas en la RNS externa (principalmente en la capa de los fotorreceptores), puede mostrar actividad incipiente de exudación (Figura 3). Asimismo, la presencia de alteraciones estructurales en el complejo EPR-Br-cc con lesiones tomográficas de reflectividad heterogénea pueden representar un complejo de vasos de neoformación a partir de la coroides17,19-21.
Figura 3. Edema de la RNS y NVC. Complejos neovasculares incipientes con aumento homogéneo de la reflectividad (a), o edema intraretiniano de las capas externas de la RNS (a), pueden observarse en los casos de proliferación angiomatosa retiniana (RAP). Quistes intraretinianos de acúmulo de fluido (b), así como tubulaciones de la retina externa (ORT) (b), pueden representar aspectos crónicos de la enfermedad. El componente cicatricial con fibrosis lesional puede verse como un aumento de la reflectividad y del grosor en el complejo EPR-Br-cc en al área subfoveal (b).
La NVC aparece como áreas de engrosamiento de la capa del EPR. Las MNVSR con componente clásico generalmente muestran una disposición de engrosamiento subretiniano más fusiforme, mientras que las MNVSR ocultas son habitualmente más irregulares y variables cuando se observan con secciones tomográficas transversales. Las NVC más profundas suelen ser poco visibles. Sin embargo, el estudio de las características de la NVC mediante OCT, para delinear y localizar las MNVSR, no es tan útil como la AGF. No obstante, cualquier modificación estructural del área macular, así como los cambios en la evolución de un EM, asociado o no a un tratamiento, son fácilmente identificables mediante OCT17,19,21.
Cualquier edema intraretiniano aparecerá como espacios quísticos en la RNS, pudiendo o no coexistir con un desprendimiento por acúmulo de FSR. Se debe tener en consideración la interpretación de los acúmulos de espacios con fluido (quistes) intraretinianos observados en el curso evolutivo de la patología, fácilmente identificables en la SD-OCT (Figura 3). Su presencia no implica necesariamente actividad de la NVC. El fluido en las capas de la RNS puede representar quistes degenerativos inactivos o tubulaciones de la retina externa, que son hallazgos comunes de los procesos degenerativos de la retina, incluyendo la DMAE (Figura 3). La correcta interpretación de los aspectos tomográficos de la retina puede evitar un tratamiento innecesario.
En las fases más avanzadas de la enfermedad, una actividad neovascular residual puede ser de difícil identificación debido al componente cicatricial o fibrótico asociado. En estos casos, las lesiones inactivas están relacionadas con hallazgos tomográficos de adelgazamiento de la RNS subyacente, mientras que los diferentes grados de actividad de la enfermedad pueden estar asociados a algún grado de aumento del grosor de la RNS, que se origina por la colección de fluido intraretiniano o subretiniano.
Las cicatrices en la retina o el EPR aparecen como áreas de mayor reflectividad de las capas externas de la retina, con áreas circundantes hiporreflectivas17,21. Los defectos angiográficos “en ventana”, correspondientes a la atrofia del EPR, muestran una retrodispersión altamente reflectante de la coroides debido al aumento de penetración de la señal en el tejido.
DMAE atrófica (atrofia geográfica)
Está caracterizada por cualquier región muy bien delineada, más o menos redonda u ovalada, de hipopigmentación o despigmentación, o con ausencia aparente del EPR, en la cual los vasos coroideos son más visibles que en las zonas circundantes. Esta región de alteración en el área macular debe tener como mínimo 175 µm de diámetro, correspondiente a aproximadamente 1/8 de diámetro del disco óptico25.La SD-OCT presenta un importante valor para el seguimiento clínico y la evolución de las alteraciones estructurales de la región macular relacionadas con los mecanismos de disminución de la visión en la atrofia geográfica. Como ya se ha mencionado, las alteraciones relacionadas con el EPR pueden identificarse como áreas focales hiperreflectivas asociadas a “sombras” ópticas adyacentes. La atrofia geográfica se identifica como un área localizada de adelgazamiento de las capas externas de la RNS y del complejo EPR-Br-cc. La coroides subyacente presenta un aumento de la reflectividad debido a una mayor penetración de la luz, por el adelgazamiento de la retina (Figura 4). Puede delimitarse la región de transición entre la retina atrófica y el tejido normal, lo que sirve como referencia de medida en los exámenes realizados de manera seriada (Figura 4). En general, el análisis del mapa de grosor de la retina permitirá evaluar el área de extensión de la región atrófica y monitorizar su progresión. No obstante, con el advenimiento de la FAF, el cálculo de la progresión del área de atrofia gana precisión. Las áreas de atrofia macular suelen presentar medidas de grosor inferiores a 190 µm, en comparación con las medidas consideradas normales, de entre 220 y 270 µm17,19,21.

Figura 4. Atrofia geográfica. Se identifica como un área localizada y bien definida de adelgazamiento generalizado de las capas externas de la RNS y del complejo EPR-Br-cc. Hay un aumento de la reflectividad de la coroides subyacente debido a una mayor penetración de la luz. Puede identificarse la región entre la retina atrófica y la retina conservada o poco afectada. Este parámetro puede ser de utilidad para el seguimiento de la progresión del área de atrofia cuando se realiza la exploración seriada en el tiempo. Se observa la progresión de la atrofia geográfica, en la que la diferencia del registro de las secciones de la OCT, en el ojo derecho (a, b) y el ojo izquierdo (c, d), es de 41 meses.
Bibliografía
- Bartlett H, Eperjesi F. Use of fundus imaging in quantification of age-related macular change. Surv Ophthalmol. 2007;52:655-71.
- Gehrs KM, Anderson DH, Johnson LV, Hageman GS. Age-related macular degeneration: emerging pathogenetic and therapeutic concepts. Ann Med. 2006;38:450-71.
- Lim LS, Mitchell P, Seddon JM, Holz FG, Wong TY. Age-related macular degeneration. Lancet. 2012;379:1728-38.
- Biarnés M, Monés J, Alonso J, Arias L. Update on geographic atrophy in age-related macular degeneration. Optom Vis Sci. 2011;88:881-9.
- Ferrara N, Mass RD, Campa C, Kim R. Targeting VEGF-A to treat cancer and age-related macular degeneration. Annu Rev Med. 2007;58:491-504.
- Olsson AK, Dimberg A, Kreuger J, Claesson-Welsh L. VEGF receptor signalling in control of vascular function. Nat Mol Cell Biol. 2006;7:359-71.
- Ng EWM, Shima DT, Calias P, Cunningham ET Jr, Guyer DR, Adamis AP. Pegaptanib, a targeted anti-VEGF aptamer for ocular vascular disease. Nat Drug Disc. 2006;5:123-32.
- Ferrara N, Damico L, Shams N, Lowman H, Kim R. Development of ranibizumab, an anti-vascular endothelial growth factor antigen binding fragment, as therapy for neovascular age-related macular degeneration. Retina. 2006;26:859-70.
- Rosenfeld PJ. New treatments for age-related macular degeneration. Lancet. 2007; 370:1479.
- Browning DJ, Kaiser PK, Rosenfeld PJ, Stewart MW. Aflibercept for age-related macular degeneration: a game-changer or quiet addition? Am J Ophthalmol. 2012;154:222-6.
- Age-related eye disease study research group (AREDS). The relationship of dietary carotenoid and vitamin A, E, and C intake with age-related macular degeneration in a case-control study: AREDS report No. 22. Arch Ophthalmol. 2007;125:1225-32.
- Age-related eye disease study 2 research group (AREDS2). Effect of long-chain ω-3 fatty acids and lutein + zeaxanthin supplements on cardiovascular outcomes: results of the Age-Related Eye Disease Study 2 (AREDS2) randomized clinical trial. JAMA Intern Med. 2014;174:763-71.
- Pinazo-Durán MD, Gómez-Ulla F, Arias L, Araiz J, Casaroli-Marano R, Gallego-Pinazo R, et al. Do nutritional supplements have a role in age macular degeneration prevention? J Ophthalmol. 2014. doi:10.1155/2014/901686.
- Kanagasingam Y, Bhuiyan A, Abràmoff MD, Smith RT, Goldschmidt L, Wong TY. Progress on retinal image analysis for age related macular degeneration. Prog Retin Eye Res. 2014;38:20-42.
- Zarbin MA, Casaroli-Marano RP, Rosenfeld PJ. Age-related macular degeneration: clinical findings, histopathology and imaging techniques. Dev Ophthalmol. 2014;53:1-32.
- Staurenghi G, Sadda S, Chakravarthy U, Spaide RF. Proposed lexicon for anatomic landmarks in normal posterior segment Spectral-Domain Optical Coherence Tomography: the IN•OCT Consensus. Ophthalmology. 2014;19. doi: 10.1016/j.ophtha.2014.02.023.
- Keane PA, Patel PJ, Liakopoulos S, Heussen FM, Sadda SR, Tufail A. Evaluation of age-related macular degeneration with optical coherence tomography. Surv Ophthalmol. 2012;57:389-414.
- Arevalo JF, Lasave AF, Arias JD, Serrano MA, Arevalo FA. Clinical applications of optical coherence tomography in the posterior pole: the 2011 José Manuel Espino Lecture – Part II. Clin Ophthalmol. 2013;7:2181-206.
- Zweifel SA, Imamura Y, Spaide TC, Fujiwara T, Spaide RF. Prevalence and significance of subretinal drusenoid deposits (reticular pseudodrusen) in age related macular degeneration. Ophthalmology. 2010;119:1775-81.
- Freund KB, Zweifel SA, Engelbert M. Do we need a new classification for choroidal neovascularization in age-related macular degeneration? Retina. 2010;30:1333-49.
- García-Layana A, Gallego-Pinazo R, Díaz-Llopis M, et al. Degeneración macular asociada a la edad. En: Muñoz-Negrete FJ, Rebolleda G, Díaz-Llopis M, editores. Tomografía de coherencia óptica. LXXXVII Ponencia Oficial de la Sociedad Española de Oftalmología, 2011. p. 281-324.
- Mrejen S, Sarraf D, Mukkamala SK, Freund KB. Multimodal imaging of pigment epithelial detachment: a guide to evaluation. Retina. 2013;33:1735-62.
- Gass JD, Bressler SB, Akduman L, Olk J, Caskey PJ, Zimmerman LE. Bilateral idiopathic multifocal retinal pigment epithelium detachments in otherwise healthy middle-aged adults: a clinicopathologic study. Retina. 2005;25:304-10.
- Giovannini A, Amato G, Mariotti C, Scassellati-Sforzolini B. Optical coherence tomography in the assessment of retinal pigment epithelial tear. Retina. 2000;20:37-40.
- Bird AC, Bressler NM, Bressler SB, Chisholm IH, Coscas G, Davis MD, et al. An international classification and grading system for age-related maculopathy and age-related macular degeneration. The International ARM Epidemiological Study Group. Surv Ophthalmol. 1995;39:367-74.
- Ferris FL 3rd, Wilkinson CP, Bird A, Chakravarthy U, Chew E, Csaky K, et al. Clinical classification of age-related macular degeneration. Beckman Initiative for Macular Research Classification Committee. Ophthalmology. 2013;120:844-51.